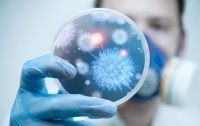
В Киеве зафиксировали новые случаи заболевания ботулизмом

ВСЕ НОВОСТИ
-
 20:48 Шоу-биз
20:48 Шоу-биз
Легендарного поп-исполнителя госпитализировали
-
 16:28 Шоу-биз
16:28 Шоу-биз
Известную певицу экстренно госпитализировали прямо с концерта
-
 08:30 Происшествия
08:30 Происшествия
Количество госпитализированных в результате стрельбы в Керчи возросло
-
 11:49 Происшествия
11:49 Происшествия
Массовое отравление в Макеевке: количество госпитализированных возросло до 43 человек
-
 18:07 Мир
18:07 Мир
В Бразилии госпитализировали еще одного кандидата в президенты
-
 19:38 Происшествия
19:38 Происшествия
На Прикарпатье из-за отравления госпитализировали шестерых людей
-
 22:03 Происшествия
22:03 Происшествия
На Львовщине госпитализировали пятерых участников свадебного застолья
-
 21:32 Происшествия
21:32 Происшествия
В Ровно 14 человек отравились на свадьбе
-
 17:44 Происшествия
17:44 Происшествия
Семью херсонцев госпитализировали с ботулизмом, муж умер
-
 17:10 Киев
17:10 Киев
Лобовое в хлам: в киевском метро иностранец бросился под поезд
-
 02:26 Происшествия
02:26 Происшествия
В Запорожье загорелось авто с водителем
-
 16:49 Мир
16:49 Мир
Пострадавший в Эймсбери снова попал в больницу
-
23:47 Киев
23:47 Киев
В Киеве зафиксировали новые случаи заболевания ботулизмом
-
 17:20 Мир
17:20 Мир
Почти 300 человек отравились в ресторане Кувейта
-
 23:39 Киев
23:39 Киев
Под Киевом школьника забрали в больницу прямо во время ВНО




